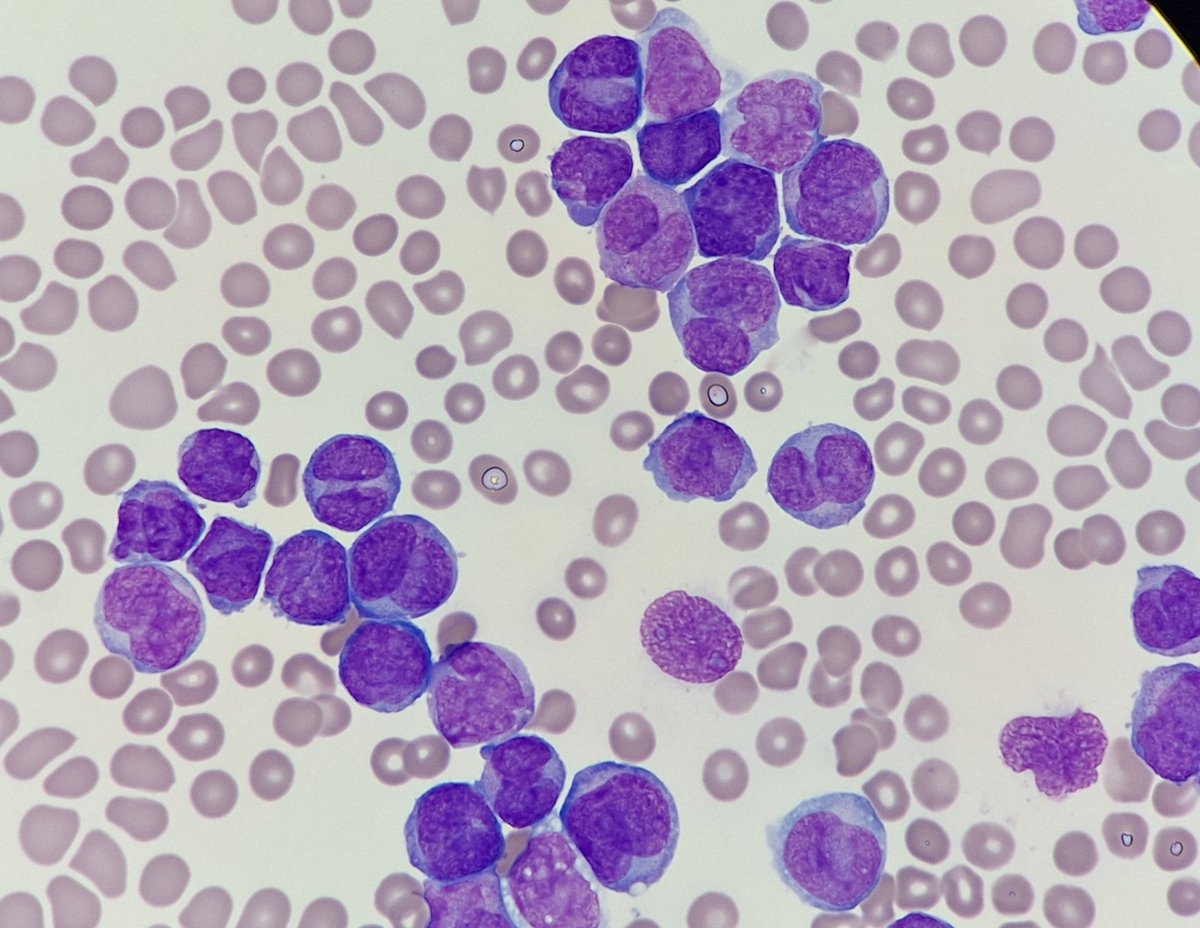

Aaron Auerbach
@aaron_auerbach
Senior Hematopathologist at the Joint Pathology Center, proponent of medical publishing and pathology lecturing; Eagles football; rock n roll; cocktails!
ID: 1234846052487794688
03-03-2020 14:20:59
492 Tweet
980 Followers
210 Following












Attending 2024 AMA Interim Meeting HOD business meeting. CAPathologists Become an ANA member, share your wisdom, contribute to medicine, and better the patients’ care.